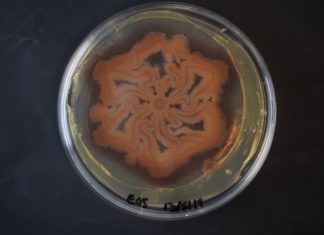
Study: New technique for engineering living materials and patterns Study: New technique for engineering living materials and patterns

Study: Telephone interventions could be used to reduce symptoms of cancer
Telephone interventions could be used to successfully treat symptoms of cancer such as fatigue, depression and anxiety, new research in the Cochrane Library reports....
Study: Why the Victoria Plate in Africa rotates
The East African Rift System (EARS) is a newly forming plate tectonic boundary at which the African continent is being separated into several plates....
Study: Protected areas worldwide at risk of invasive species
Protected areas across the globe are effectively keeping invasive animals at bay, but the large majority of them are at risk of invasions, finds...
Study: New technique for engineering living materials and patterns
Engineered living materials (ELMs) is a new class of materials that exploit the properties of living organisms
· While various techniques such as 3D printers...
Study: Eclipse data illuminate mysteries of Sun’s corona
Researchers at the University of Hawai?i Institute for Astronomy (IfA) have been hard at work studying the solar corona, the outermost atmosphere of the...
Study: Lightning fast algorithms can lighten the load of 3D hologram generation
Researchers from Tokyo Metropolitan University have developed a new way of calculating simple holograms for heads-up displays (HUDs) and near-eye displays (NEDs). The method...
Study: Great white shark diet surprises scientists
The first-ever detailed study of the diets of great white sharks off the east Australian coast reveals this apex predator spends more time feeding...
Study: PFAS present throughout the Yadkin-Pee Dee river food chain
Researchers from North Carolina State University have found per- and polyfluoroalkyl substances (PFAS) in every step of the Yadkin-Pee Dee River food chain, even...
Study: Mice are shrinking, but are climate change and cities to blame?
According to a well-studied but controversial principle known as Bergmann's Rule, species tend to be larger in cold climates and smaller in warm ones....
Mangroves at risk if carbon emissions not reduced by 2050 (Study)
Scientists from Nanyang Technological University, Singapore (NTU Singapore), and an international research team have predicted that by 2050, mangroves will not be able to...